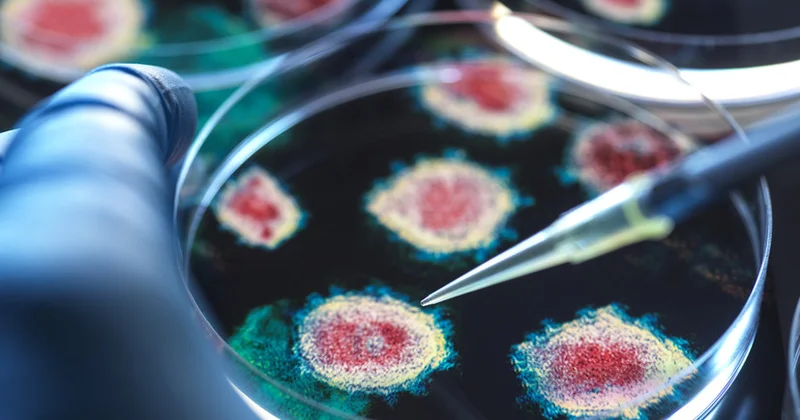
RSV virusu qrip və COVID 19 qədər təhlükəlidir alimlər xəbərdarlıq edir

SON DƏQİQƏ: İsrail Qəzzanı ağır bombalayır və tanklarla irəliləyir KONKRET
Icma.az, Konkret.az saytından verilən məlumata əsaslanaraq xəbər yayır.
Qəzzanın şimal-qərbində quru qüvvələrinin manevrləri barədə məlumat yayılıb.
KONKRET.az xəbər verir ki, bundan əlavə, şəhərin daxili hissəsinin bir sıra ərazilərində tam komendant saatı elan edilib.
İsrail Teleqraf kanalları Qəzza zolağında baş verən partlayışların İsrailin mərkəzində pəncərələri silkələdiyini iddia edir.
Ağır bombalardan, istifadə edən İsrail, həmçinin tanklarla irəliləyir.
Dəniz Pənahova
KONKRET.az
Bu mövzuda digər xəbərlər:İsrail Qəzzanı belə bombalayır VİDEO
30 Avqust 2025 21:32
İsrail Qəzzanı bombalayır Ölənlərin sayı artıb
29 Sentyabr 2025 14:29
Suriyadan SON DƏQİQƏ XƏBƏRİ: İsrail təyyarələri bombalayır
03 May 2025 08:06
İsrail hələ də Qəzzanı bombalayır Ölənlər var
06 Oktyabr 2025 00:05
SON DƏQİQƏ! ABŞ təsdiqlədi İsrail Qəzzada… KONKRET
30 May 2025 08:21
Baxış sayı:46
Bu xəbər 16 Sentyabr 2025 00:48 mənbədən arxivləşdirilmişdir



Daxil ol
Xəbərlər
Hava
Maqnit qasırğaları
Namaz təqvimi
Qiymətli metallar
Valyuta konvertoru
Kredit Kalkulyatoru
Kriptovalyuta
Bürclər
Sual - Cavab
İnternet sürətini yoxla
Azərbaycan Radiosu
Azərbaycan televiziyası
Haqqımızda
TDSMedia © 2025 Bütün hüquqlar qorunur







Günün ən çox oxunanları